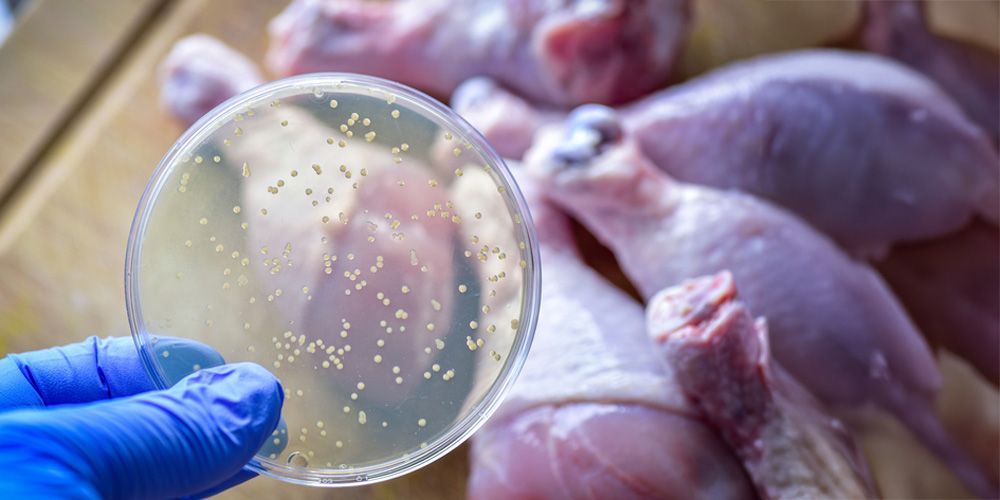
Reduce Food Contamination

Why Pest Control in Tulsa is Essential for Your Home’s Safety
In Oklahoma, pest control is crucial throughout the year. The warm, humid climate keeps pests active in every season, making it essential for homeowners to keep up with pest management. Areas like Tulsa experience frequent issues with pests, including ants, termites, cockroaches, spiders, and silverfish, which can invade homes and cause various problems. Tulsa pest control should be integral to regular home maintenance to protect families and property.
There are several vital reasons why pest control in Tulsa is necessary, ranging from health concerns to property damage prevention. So, if you're questioning the need for pest control, here are seven compelling reasons to make it part of your home care routine.

Protect Your Family's Health
Pests carry harmful bacteria, allergens, and diseases that can affect your family's health. For example, cockroaches spread pathogens like Salmonella and E. coli, contaminating surfaces and food. These pathogens can poison food and lead to other gastrointestinal illnesses. Conversely, rodents leave behind urine and droppings that transmit diseases such as hantavirus and leptospirosis.
Moreover, pests can worsen respiratory issues. Cockroach allergens, found in their droppings and shed skins, can aggravate asthma and allergies, particularly in children. Rodents also produce dander that becomes airborne and triggers respiratory problems. Pest control in Tulsa directly addresses these issues by eliminating the pests that bring these health risks into your home.
Investing in professional pest control in Tulsa can create a safer environment for your family. Regular services ensure the treatment of high-risk areas, reducing the presence of pests that spread diseases and exacerbate respiratory conditions. Consistent pest management becomes necessary with Tulsa's warm and humid climate encouraging year-round pest activity.

Prevent Costly Structural Damage
Termites and carpenter ants are silent destroyers, eating away at your home's structural components without immediate detection. Termites tunnel through wood, compromising the integrity of walls, beams, and foundations. If left untreated, their damage can result in thousands of dollars in repairs. While less aggressive, Carpenter ants burrow through wood to create nests, weakening wooden structures.
Rodents also contribute to structural damage by gnawing on electrical wires, insulation, and wood. This weakens your home and increases the risk of electrical fires. Regular pest control in Tulsa helps identify and address these pests before they cause irreversible damage to your property.

Preserve Your Property Value
A pest-free home retains its value better in the real estate market. Visible signs of pests, like termite damage or rodent infestations, can deter potential buyers or lead to lower offers during a sale. Termites, in particular, signal underlying structural issues buyers may not want to address.
Even less destructive pests, like ants or cockroaches, can make a bad impression during property showings. Thus, maintaining consistent pest control in Tulsa ensures your home remains attractive to buyers and appraisers, preserving its market value over time.
Reduce Food Contamination
If left unprotected, your kitchen and pantry can become hotspots for pest activity. Ants and cockroaches are particularly drawn to food, crawling through unsanitary areas before contaminating your supplies. Rodents can chew through food packaging, leaving droppings that make food unsafe.
Pest control in Tulsa helps protect your food by identifying and sealing entry points and eliminating pests that invade your pantry. Additionally, it is wise to store your food in sealed containers, which act as an extra layer of protection against contamination.

Prevent Seasonal Pest Migration
As temperatures change, pests like rodents, spiders, and ants seek refuge indoors. They enter through cracks, vents, and poorly sealed windows to escape the cold or heat outside. Without pest control, these seasonal migrations can lead to nests and infestations that overgrow and are out of control.
For instance, rodents can nest in attics, walls, or basements, while spiders create webs in hidden corners. By investing in professional pest control in Tulsa, you can seal off entry points and apply preventive treatments that keep these pests from moving in during seasonal shifts.

Minimize Pest Reproduction
Many pests reproduce quickly, making infestations harder to control if left untreated. For example, cockroaches can produce hundreds of offspring in just a few months. Similarly, rodents can have multiple litters per year, leading to a population explosion if not managed.
Tulsa pest control disrupts these breeding cycles, targeting pests at all life stages. Professional treatments eliminate adult pests, larvae, and eggs, ensuring the infestation doesn't regenerate. By staying ahead of pest reproduction, you avoid the frustration and expense of dealing with large-scale infestations.

Protect Your Peace of Mind
Living with pests can cause unnecessary stress. Constantly worrying about pest sightings, bites, or damage can make your home feel less like a sanctuary and more like a battleground. For example, finding a cockroach in your kitchen or hearing rodents in the walls can disrupt your daily routine and sleep.
Regular pest control in Tulsa ensures you don't have to deal with these unsettling experiences. Knowing that professionals are handling the issue gives you the confidence to enjoy your home without fear of infestations. It's about creating a clean, comfortable space where you and your family can relax.

Why Choose Professional Pest Control in Tulsa?
Is professional pest control in Tulsa, OK, worth it? Many homeowners find it valuable, especially when faced with a current infestation or as a preventative measure. Tackling pest issues alone can be challenging; identifying the correct treatment requires expertise. If pests detect a threat but are not eliminated, they may relocate, which could exacerbate the problem.
Thus, hiring a reputable pest control provider in Tulsa resolves pest issues quickly and efficiently. Their expertise and specialized equipment make them the best choice for a pest-free home.
References:
Asthma triggers: gain control | US EPA. (2024, April 3). Retrieved from https://www.epa.gov/asthma/asthma-triggers-gain-control
Donkor, E. S. (2020). Cockroaches and food-borne pathogens. Environmental Health Insights, 14, 117863022091336. https://doi.org/10.1177/1178630220913365
Donnelly, T. M., Bergin, I., & Ihrig, M. (2015). Biology and diseases of other rodents. In Elsevier eBooks (pp. 285–349). https://doi.org/10.1016/b978-0-12-409527-4.00007-9